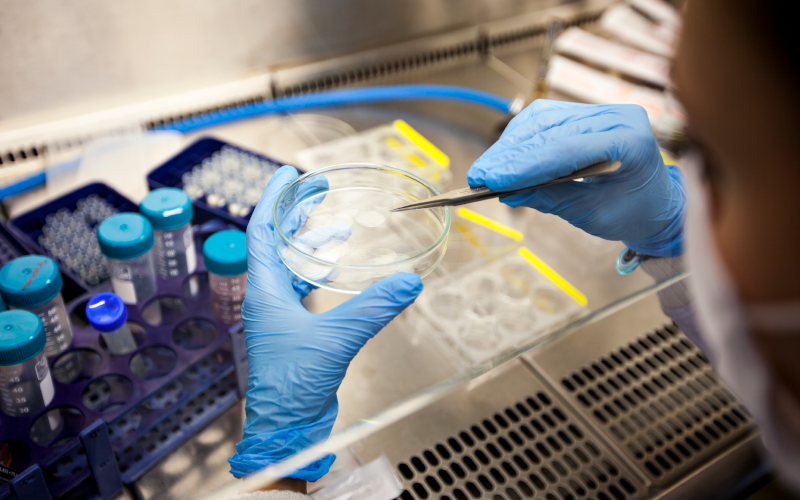
Young doctor researches in lab

A world where chronic illnesses are not just managed but potentially cured, where damaged tissues and organs can be regenerated, and where personalised medicine is the norm rather than the exception, is not the realm of science fiction but an emerging reality. This transformation is driven by the convergence of regenerative medicine and pharmaceutical sciences. In a hospital in the near future, a patient with heart disease might receive a bioengineered heart, while another with diabetes could benefit from a pharmaceutical breakthrough that enhances the body’s ability to regenerate pancreatic cells. These scenarios, once considered speculative, are rapidly becoming possible through innovative cross-disciplinary research and technological advancements.
At the heart of this transformation lies a synergistic relationship between regenerative medicine and pharmaceutical sciences. Pharmaceutical sciences, grounded in chemistry and biology, have been instrumental in developing treatments that alleviate symptoms and improve quality of life. Regenerative medicine, utilising cutting-edge techniques such as stem cell therapy, tissue engineering, and genetic editing, seeks to restore function by repairing or replacing damaged tissues and organs. When combined, these fields promise to revolutionise medical treatment by creating therapies that are not only more effective but also more tailored to individual patient needs.